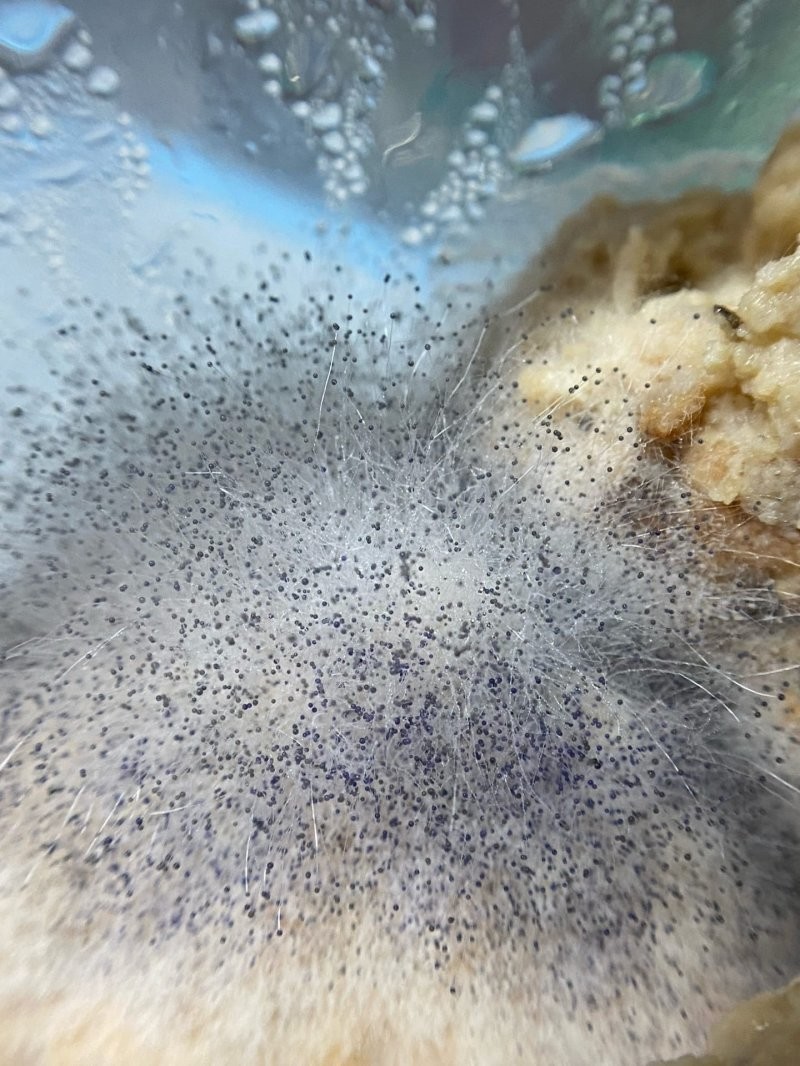

Люди делятся в интернете плесенью, которую обнаружили или вырастили (17 фото)
Каждый из нас хоть раз, да встречал плесень. Забытая еда, старые вещи — плесень окружает нас всюду. Но, кроме того, что плесень может быть не приятной, она ещё и красивая! 
В интернете есть группа "Мама, я вырастил плесень", где пользователи рунета делятся своей плесенью. У кого-то она выросла сама, кто-то ещё обнаружил, а есть и такие, которые сами её вырастили специально. Что уж говорить, но плесень может быть очень красивой!
"Голова подсолнечника была забыта в духовке на месяц" 
"Первый случай, когда котлеты эволюционировали обратно в нечто живое"
"До возвышения плесенью это был чай" 
"Плесень в гейзерной кофеварке. Красивенько выросла под прессом верхней колбы" 
"Овсянка, сэр!" 
"На малосольных огурчиках домашнего производства" 
"Вырастила новые нейронные связи" 
"Забытый в недрах стеллажа велюр из белого шоколада превратился в грибную Луну ?" 
"Забытый в вазе букет..." 
"Это были каннеллони" 
"Молочный улун с любовью" 
"Два месяца трудов, и вот, наконец, выросла кастрюлька отборной плесени" 
"Я вырастил" 
"Очаровательный мир плесневелой браги" 
"Когда-то это были соленые огурчики)" 
"Тянутся к небу" 


















